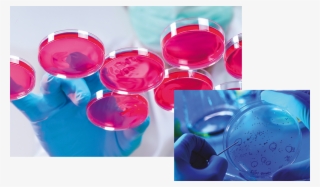
Agar - Cell #7995747

-
Cellphone Signal Booster - Cell Phone Booster Rv
600*600
2
1
-
Location - Plant Cell
660*527
2
1
-
Location - Plant Cell
1024*808
2
1
-
Immune Cells
600*600
1
1
-
Sticker Color Chart - Cell Phone Number Pad
700*678
2
1
-
Blood Donation Download Png Image - Red Blood Cell Png
1000*1000
3
1
-
Diagram Of A Labeled Nerve Cell
945*497
3
1
-
Motor Neurone Disease Cell
640*480
2
1
-
Agar - Cell
1000*586
1
1
-
Straight Talk Cell Phones
804*476
2
1
-
Madara With Hashirama Cells
988*741
2
1
-
Jail Png Hd - Jail Cell Clipart
800*800
2
1
-
1024 X 607 2 - Solar Cell Module Array
1024*607
2
1
-
Industrial Robotic Work Cell Enclosure Design
1200*630
1
1
-
Jail Bars - Real Jail Cell Bars
640*480
4
2
-
Animal Cell Clip Art
558*596
2
1
-
Bone Vs - Cartilage - Cartilage Cell Diagram
2000*1115
1
1
-
Image - Wiki - Loss In Solar Cell
969*720
1
1
-
Recent Images - Please Silence Your Cell Phone
833*762
1
1
-
Cellet Cell Phone Case For Iphone 7 - California
1200*800
3
1
-
Line Icon Png Transparent Icon
866*650
0
0
-
Selo Inhibits Cell Line Viability
850*748
2
1
-
Cell Cell Avidity Based Screening Sorting Z Movi
2656*1317
3
1
-
The Mustard Oil Bomb - Myrosinase Broccoli
697*516
1
1
-
Cell Phone Icon Png Hd
547*1024
7
3
-
Cell Phone Icon Png Clipart Best - Apple Iphone 3g Png
1024*1024
11
3
-
Cell Phone Cover
1000*1000
4
1
-
Monster Cells - Drawing
486*750
3
1
-
Cell Phone Number - Icon For Mobile Number
606*980
6
2
-
Cell Phone Pose - Mobile Phone
526*1053
6
1
-
Cell Phone Repair Png
450*300
5
2
-
Png Free Stock Cells Drawing Gohan - Line Art
3588*5000
7
1
-
Huawei Y6 2018 Cell Phone Black - Huawei Y6
400*400
4
1
-
Cell Shaded - Cartoon
491*810
3
1
-
Peace Sign Hippie Cell Phone Case - Hippie
390*390
5
1
-
Cell Phone Clipart Png
464*600
4
1
-
Cell Phones - Iphone
718*659
3
1
-
Jeremy Clarkson Cell Phone Case Ballzbeatz
1285*1285
4
1